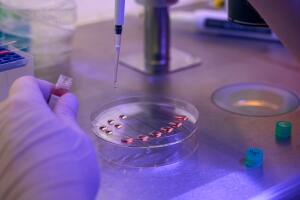
Campaign Microscopy Medical Science 4

Get started with your digital microscopy project
Quick start with Allied Vision cameras and µManager

Maximize Production Efficiency And Minimize Downtime
With our open source µManager plugin, all our cameras can now be easily used in a variety of microscopy imaging applications. Important functionalities such as real-time control, live preview, time-lapse and multi-channel imaging as well as Z-stacking and other advanced functions are accessible. This powerful combination enables the capture of high-quality images and optimizes microscopy workflows for greater efficiency and precision. Thanks to the plug-and-play user interface, the cameras are easy to operate and configure, ensuring a unique user experience. Benefit from the wide variety of our cameras, which support different wavelength ranges from UV to eXtended SWIR.
Especially our SWIR cameras play a vital role in SWIR microscopy due to the higher penetration depth of light. Equipped with highly sensitive InGaAs sensors and thermo-electric cooling they provide outstanding images with low noise. This enables, for example, to gain detailed insights about tissue structures beneficial to identify tumors, as certain types of tissue absorb and reflect SWIR light differently.
Integrate your Allied Vision camera seamlessly into your microscopy imaging application!
- Medical Imaging:
Surgical Microscopy, Dental, Ophthalmology, Clinical Pathology, Cell Culture, Oncology, - Life Science Imaging:
Live Cell Imaging, Neuroscience, Virology, Cell Biology, Pathology - Industry:
Material Analysis, Quality Control, PCB inspection, Semiconductor Wafer Processing, IC Packaging, IC Assembly and Testing
Interested? Contact Us
Any questions about cameras for your microscopy imaging application?